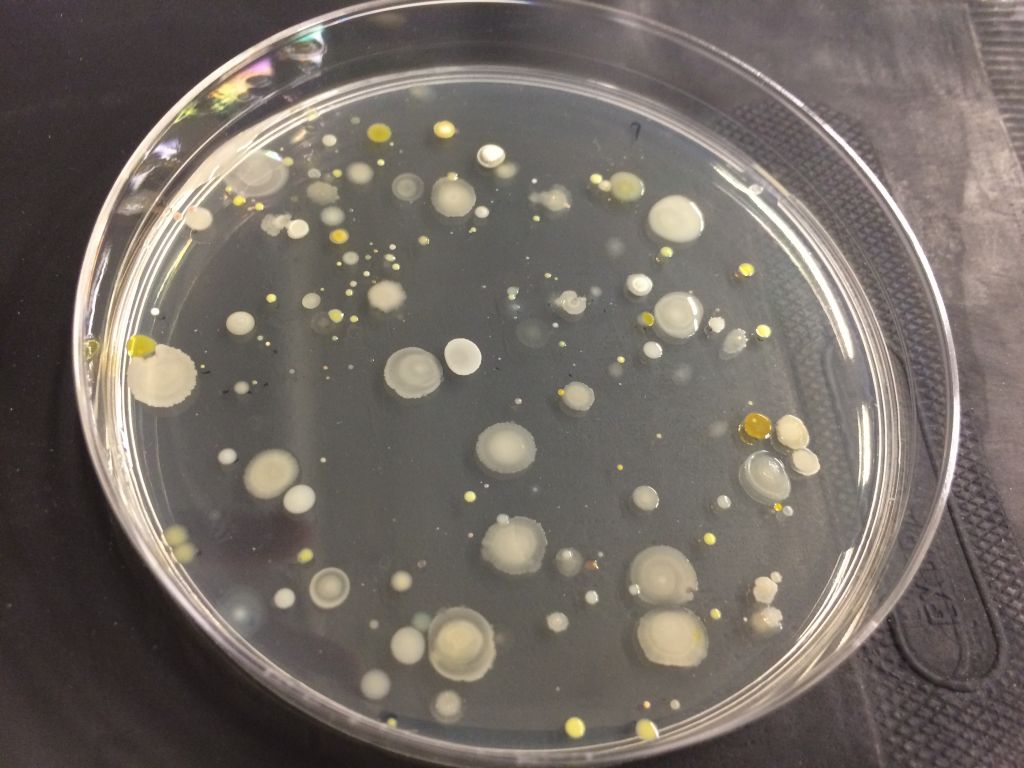

bacteria trufa
Los investigadores sobre cultivos de Tuber melanosporum están trabajando con las bacterias ya presentes en la propia trufa con el fin de incrementar el nivel de producción de las encinas en el campo. La trufa es un hongo que crece asociado a la raíz de un árbol y cualquier afección en la carrasca puede repercutir en el desarrollo de la micorriza. Por eso se trata de un cultivo en el que no se añaden fertilizantes ni sulfatos que puedan perjudicar esa delicada simbiosis. Los trabajos científicos desarrollados al respecto por la empresa catalana Micología Forestal y Aplicada tienen que ver principalmente con bacterias que están ya en la trufa de forma que no le provocan daños.
